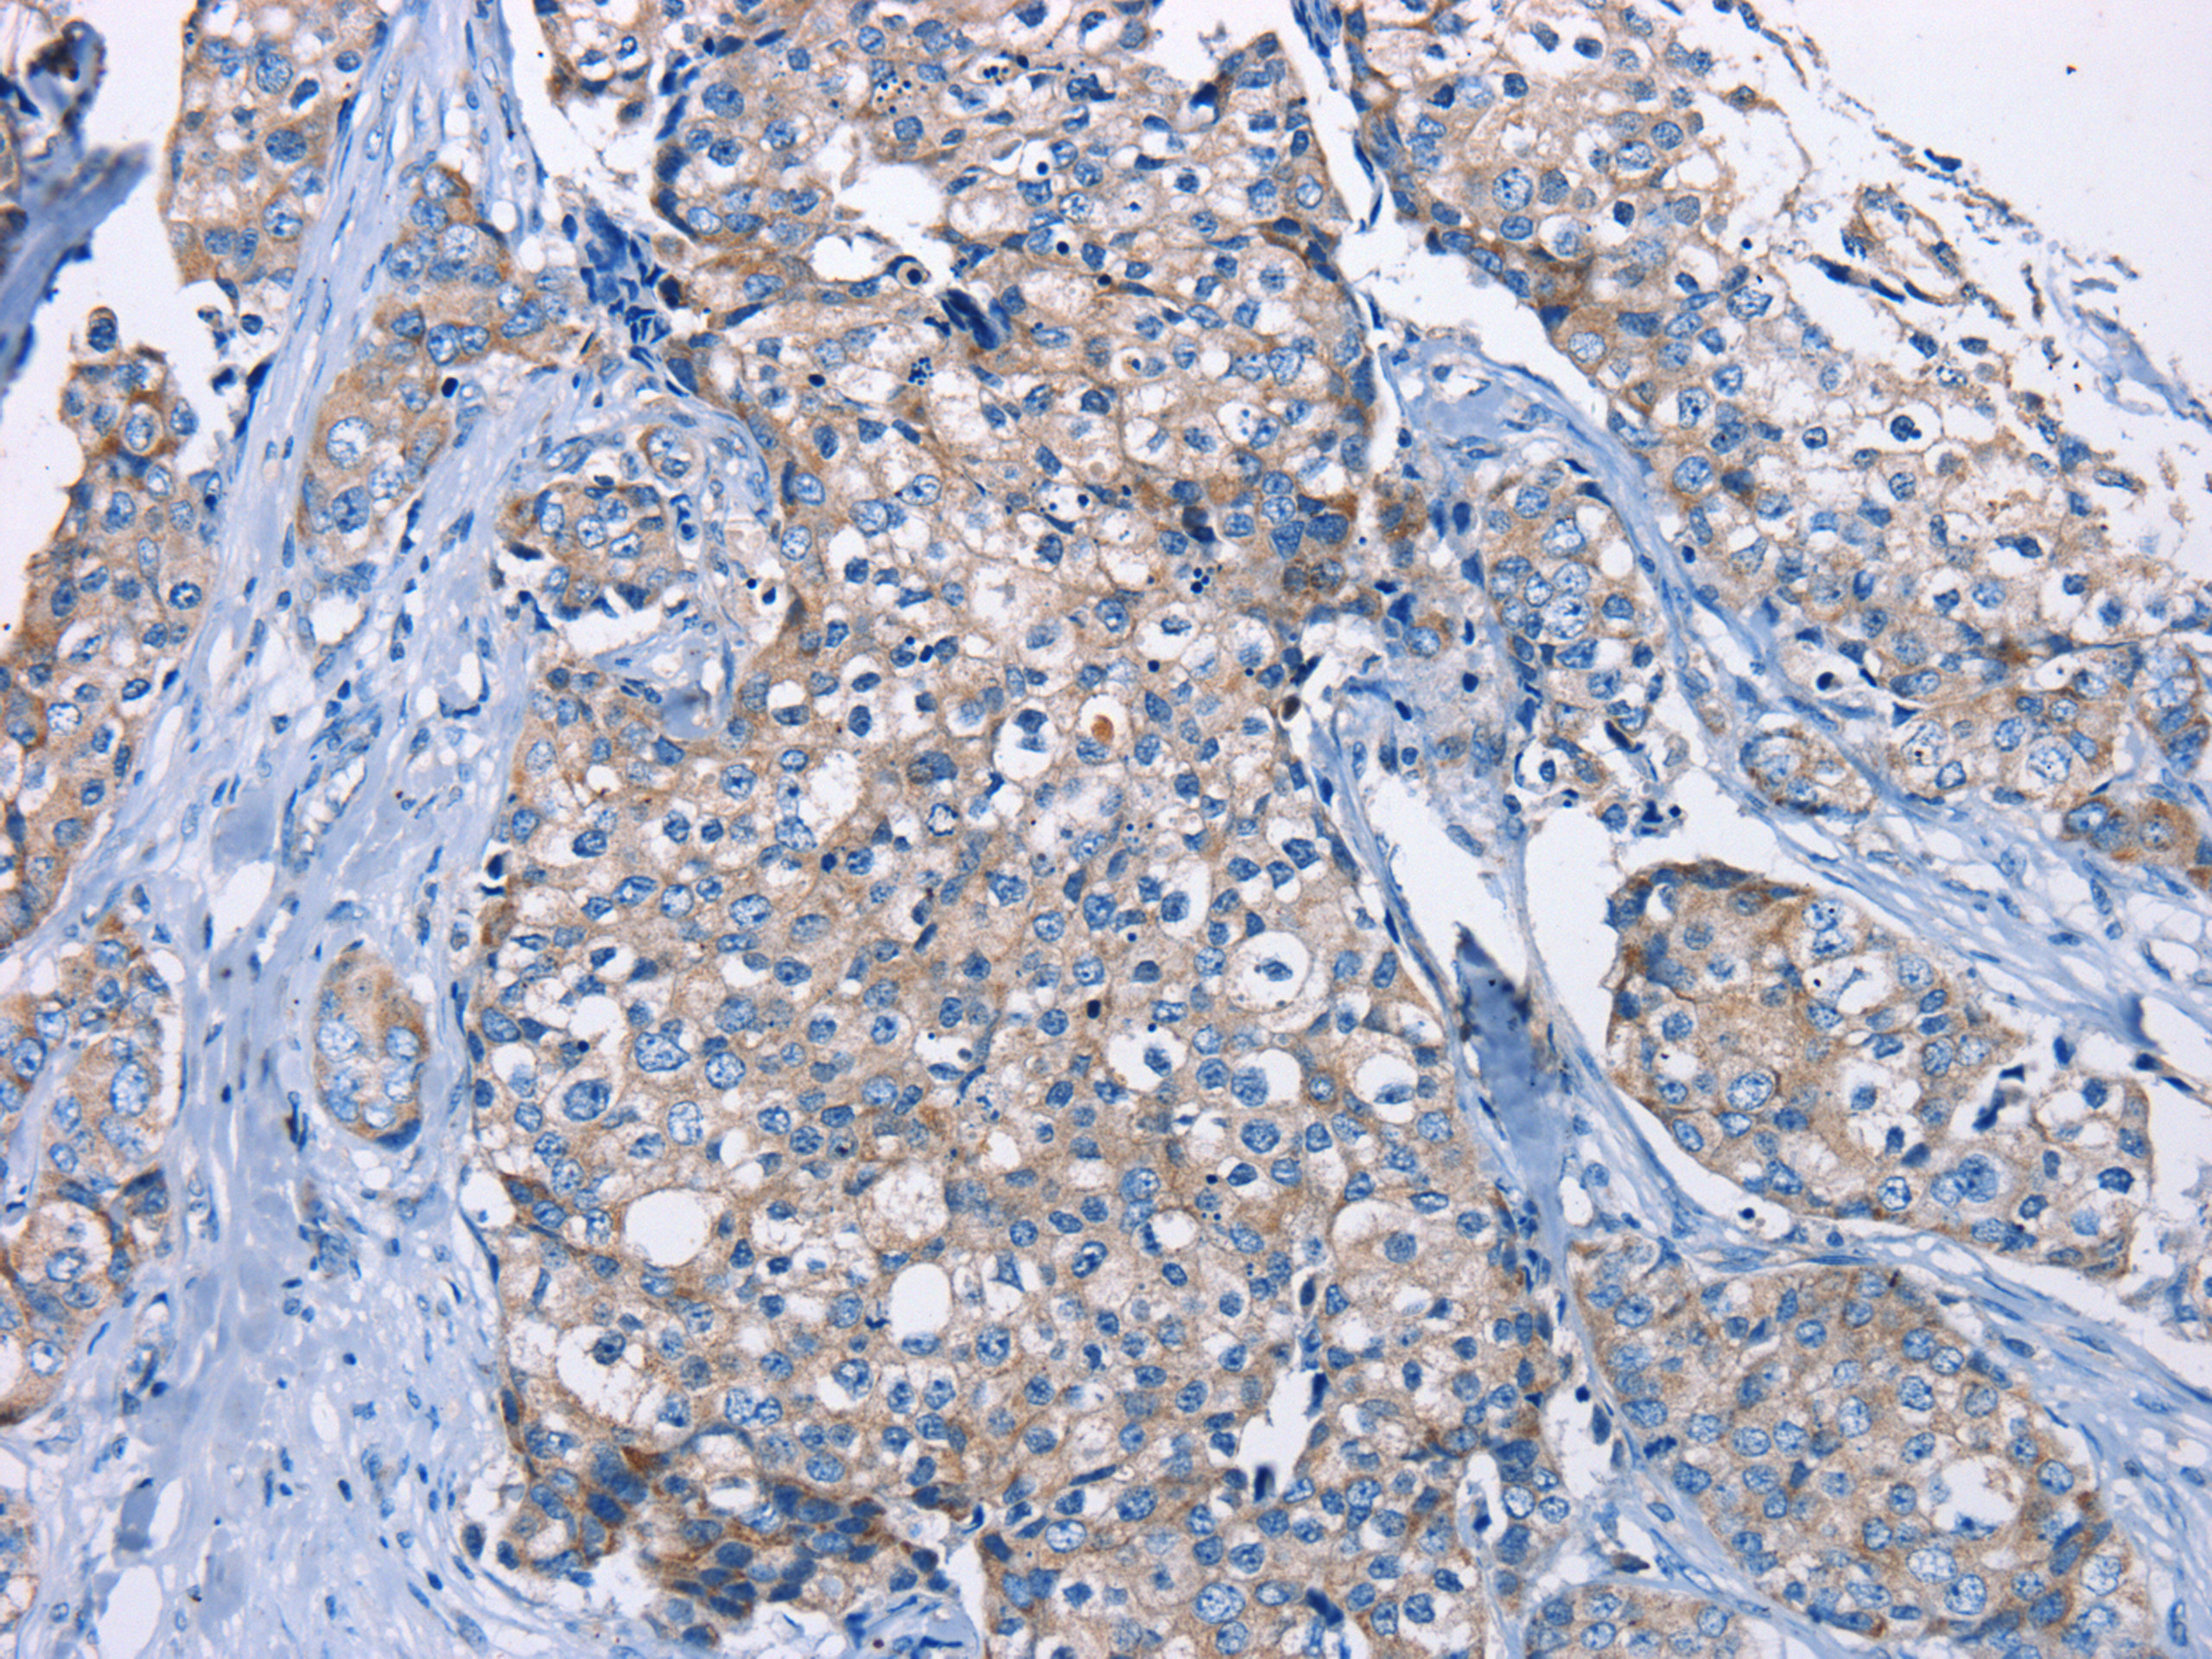

DMD Antibody
-
中文名稱:DMD兔多克隆抗體
-
貨號(hào):CSB-PA503789
-
規(guī)格:¥1100
-
圖片:
-
The image on the left is immunohistochemistry of paraffin-embedded Human breast cancer tissue using CSB-PA503789(DMD Antibody) at dilution 1/30, on the right is treated with fusion protein. (Original magnification: ×200)
-
The image on the left is immunohistochemistry of paraffin-embedded Human brain tissue using CSB-PA503789(DMD Antibody) at dilution 1/30, on the right is treated with fusion protein. (Original magnification: ×200)
-
-
其他:
產(chǎn)品詳情
-
Uniprot No.:
-
基因名:
-
別名:BMD antibody; CMD3B antibody; DMD antibody; DMD_HUMAN antibody; Duchenne muscular dystrophy protein antibody; Dystrophin antibody; Muscular dystrophy Duchenne and Becker types antibody
-
宿主:Rabbit
-
反應(yīng)種屬:Human,Mouse
-
免疫原:Fusion protein of Human DMD
-
免疫原種屬:Homo sapiens (Human)
-
標(biāo)記方式:Non-conjugated
-
抗體亞型:IgG
-
純化方式:Antigen affinity purification
-
濃度:It differs from different batches. Please contact us to confirm it.
-
保存緩沖液:-20°C, pH7.4 PBS, 0.05% NaN3, 40% Glycerol
-
產(chǎn)品提供形式:Liquid
-
應(yīng)用范圍:ELISA,IHC
-
推薦稀釋比:
Application Recommended Dilution ELISA 1:1000-1:2000 IHC 1:25-1:100 -
Protocols:
-
儲(chǔ)存條件:Upon receipt, store at -20°C or -80°C. Avoid repeated freeze.
-
貨期:Basically, we can dispatch the products out in 1-3 working days after receiving your orders. Delivery time maybe differs from different purchasing way or location, please kindly consult your local distributors for specific delivery time.
-
用途:For Research Use Only. Not for use in diagnostic or therapeutic procedures.
相關(guān)產(chǎn)品
靶點(diǎn)詳情
-
功能:Anchors the extracellular matrix to the cytoskeleton via F-actin. Ligand for dystroglycan. Component of the dystrophin-associated glycoprotein complex which accumulates at the neuromuscular junction (NMJ) and at a variety of synapses in the peripheral and central nervous systems and has a structural function in stabilizing the sarcolemma. Also implicated in signaling events and synaptic transmission.
-
基因功能參考文獻(xiàn):
- Case Report: dystrophin mutation (p.1667 del Ala), resulting in Becker muscular dystrophy-associated cardiomyopathy that demonstrated the pathological features of significant fibrofatty replacement in the sub-epicardial layer of the ventricle. PMID: 30103083
- DMD gene mutations involving the hinge 3 region, actin-binding domain, and exons 45-49, as well as the LTBP4 IAAM haplotype, were not associated with age of left ventricular dysfunction onset inDuchenne muscular dystrophy. PMID: 29766838
- we found a new 9358-9359insA mutation of the dystrophy gene in a Chinese boy with muscular dystrophy and his mother PMID: 29336709
- Mutation spectrum analysis of DMD gene causing Duchenne/Becker muscular dystrophy in 68 families in Kuwait has been reported. PMID: 29847600
- Low dystrophin expression is associated with Becker and Duchenne muscular dystrophy. PMID: 29641567
- This study characterize the developmental profile of dystrophin expression across human brain regions to define the temporal profile of astrocytic endfoot development. PMID: 28509351
- A novel small mutation in the first exon-intron boundary splicing site of the DMD gene was found, in a patient with higher serum CK level in his family. This small mutation is responsible for X-linked dilated cardiomyopathy. PMID: 29901616
- new mutations in Duchenne muscular dystrophy/Becker muscular dystrophy patients with deletions were significantly more frequent than in those with duplications and small mutations. PMID: 28680110
- Ambulant and steroid naive Japanese Duchenne muscular dystrophy was shown significantly shorter than normal. In addition, Becker muscular dystrophy was slightly shorter than normal. This suggested that levels of dystrophin expression is associated with short stature. The fact that the higher incidence of the short stature was observed in Dp71 subgroup suggested a role of Dp71 in growth. PMID: 28734761
- Data indicate that Becker muscular dystrophy (BMD) patients carrying deletions of the rod domain of the exons in dystrophin gene. PMID: 29419852
- It has been concluded that patients with dystrophin "del x-51" or "del 48" mutations have mild or asymptomatic Becker muscular dystrophy, while "del 45-x" mutations cause comparatively severe weakness, and functional deterioration in 1 year. PMID: 27582364
- The study and validation of DMD as a new player in tumor development and as a new prognostic factor for tumor progression and survival are warranted. PMID: 27391342
- The entire DMD locus is dynamically transcribed by the RNA pol II; mechanisms involved in dystrophin gene expression control. PMID: 28867298
- suggests that Dp71-lamin B1 protein complex plays an important role for the newly identified tumor suppressive function of Dp71 PMID: 27449096
- Via increasing FAK in the cytoplasmic FAK-Dp71 , lamin B1 of nucleus laminB1-Dp71 complex, HBE-Dp71d and HBE-Dp71f cells alter their proliferation, migration, invasion, cell cycle and apoptosis rate induced by H2O2. PMID: 29059680
- Hence MyoD-transformed cells may be a good myogenic model for studying dystrophin gene expression, and native urine stem cells could be used to study the dystrophin transcript, and both diagnostic procedures and splicing modulation therapies in both patients and control subjects, without invasive and costly collection methods PMID: 27530229
- The de novo deletion of exons 17 to 29 of the DMD gene detected in the fetus may result in BMD or DMD. PMID: 28777860
- recent work demonstrating that multi-step events are required for long DMD intron removal. The role of temporary intron retention in the occurrence of alternative splicing events is also discussed. PMID: 28597072
- Study provides evidence that dystrophin contains multiple independent membrane-binding domains. These structurally and functionally distinctive membrane-binding domains provide a molecular framework for dystrophin to function as a shock absorber and signaling hub. PMID: 27378693
- ultiplex ligation-dependent probe amplification combined with next-generation sequencing was effective for detection of the mutations in dystrophin gene exons in patient with Duchenne and Becker muscular dystrophies. PMID: 27750387
- a very infrequently reported deletion of a single exon 48 of the dystrophin gene caused a subclinical or very mild form of Becker muscular dystrophy in nine non-consanguineous families PMID: 28247318
- This study describe a series of patients of Greek origin who carry a c.5068_5070delCAC mutation in the DMD gene. PMID: 27178005
- These data support the hypothesis that skewed XCI is involved in the onset of phenotype in DMD carriers, the X chromosome carrying the normal DMD gene being preferentially inactivated and leading to a moderate-severe muscle involvement. PMID: 27098336
- DMD reversion leads to somatic mosaicism in DMD patient. PMID: 26956251
- In this study, we focused on the phenotype of patients with BMD, who had in-frame deletion starting at exon 45 of the DMD gene, to investigate the appropriate restoration of the reading frame by exon skipping therapy PMID: 27974813
- It concluded that Dp71, comprising Dp71b and Dp71ab, was expressed exclusively in HEK293 cells and that Dp71ab was specifically localized to the nucleus. Our findings suggest that Dp71ab in the nucleus contributes to the diverse functions of HEK293 cells. PMID: 27109495
- This study aimed to provide in vitro quantitative evidence of the ability of human mesoangioblasts to restore dystrophin, in terms of protein accumulation and distribution, within myotubes derived from patients with Duchenne muscular dystrophy. PMID: 27502519
- In TMD patients, a novel locus at genome-wide level of significance (rs73460075, OR = 0.56, P = 3.8 x 10(-8)) in the intron of the dystrophin gene DMD (X chromosome), and a suggestive locus on chromosome 7 (rs73271865, P = 2.9 x 10(-7)) upstream of the Sp4 Transcription Factor ( SP4) gene were identified in the discovery cohort, but neither of these was replicated. PMID: 28081371
- As exon 44 skipping-amenable DMD has a later loss of ambulation, mutation-specific randomization and selection of placebo groups are essential for the success of clinical trials PMID: 27343068
- We focused on four prevalent mutated proteins deleted in RDelta45-47, RDelta45-48, RDelta45-49, and RDelta45-51, analyzing protein/membrane interactions. Mutants RDelta45-48 and RDelta45-51 led to mild pathologies and displayed a similar triple coiled-coil structure as the full-length DYS R16-21, whereas the two others, RDelta45-47 and RDelta45-49, induced more severe pathologies and showed "fractional" structures unre... PMID: 27367833
- The dystrophin expression plasmids described here will be useful in cell and gene therapy studies aimed at ameliorating Duchenne muscular dystrophy PMID: 28139886
- In Korean boys, 117 different deletions, 48 duplications, and 90 pathogenic sequence variations, including 30 novel variations, were identified. Deletions and duplications accounted for 65.4% and 13.3% of Korean dystrophinopathy, respectively, suggesting that the incidence of large rearrangements in dystrophin is similar among different ethnic groups. PMID: 27593222
- Detected are the expression of endogenous exons 44-56 connected mRNA transcript of the DMD using total RNAs derived from human normal skeletal muscle by reverse transcription polymerase chain reaction and identified are a total of eight types of multiple exon skipping products around the mutation hotspot. PMID: 27754374
- Multiplex Ligation Probe Amplification identified 56 mutations (45 deletions, 9 duplications and 2 point mutations), confirmed the clinical diagnosis in 63% (51/81) of patients and symptomatic females, established the carrier status of 54% (20/37) of females at-risk and 3 male villus samples, established an association between the most frequent deletion intron breakpoints and the abundance of dinucleotide microsatellites PMID: 27206868
- Thus using NGS we have identified a pathogenic DMD mutation from degraded DNA and low-level somatic mosaicism, which would have been overlooked using Sanger sequencing. PMID: 26740235
- Four nonsense, one frameshift and two splice site mutations as well as two missense variants have been found in dystrophin gene in Iranian Duchenne and Becker muscular dystrophy patients. PMID: 27350676
- Four missense mutations (p.Arg2937Gln, p.Asp882Gly, p.Lys2366Gln, and p.Arg1745His) that are known multiple-polymorphic sites were found in the coding region of the DMD gene. A hemizygous splicing mutation IVS44ds +1G-A (c.6438 +1G>A) was located in intron 44. PMID: 27421007
- Results provide evidence for recursive splicing in the dystrophin transcript and that the order at which introns are removed is not consecutive. PMID: 26670121
- DMD mutations affecting different DMD isoforms associate with characteristically abnormal scotopic ERGs and severe neurodevelopmental problems in Duchenne muscular dystrophy patients. PMID: 26081639
- DMD gene mutations may be suspected in girls child with persistently elevated levels of creatine kinase and scoliosis, calf hypertrophy, or myopathic pattern at electromyography. PMID: 26718981
- the deletion patterns and distribution characteristics of the dystrophin gene in a Chinese population of patients with Duchenne muscular dystrophy (DMD) or Becker muscular dystrophy, are reported. PMID: 26786758
- The range of phenotypes associated with the region Xp21 has been expanding. Mild end of the spectrum includes phenotype of the muscle cramps with myoglobinuria and isolated quadriceps myopathy, at the severe end, there are progressive muscle diseases. PMID: 25416089
- attention should be paid to the possibility of severe arrhythmias in the severe phenotype of Becker muscular dystrophy PMID: 26631896
- Males with mutations at the 3' end of the DMD gene affecting all protein isoforms have higher rates of intellectual disability and clusters of neurodevelopmental, emotional, and behavioural symptoms in Duchenne muscular dystrophy. PMID: 26365034
- Study determined the frequency of dystrophin gene alterations in Iranian Duchenne and Becker muscular dystrophies patients using two new proposed sets of primer pairs of M-PCR to facilitate further mutation detection in patients and their families PMID: 26081009
- Correlation of Utrophin Levels with the Dystrophin Protein Complex and Muscle Fibre Regeneration in Duchenne and Becker Muscular Dystrophy Muscle Biopsies. PMID: 26974331
- Mutations of Dystrophin and Duchenne and Becker muscular dystrophies (review). PMID: 26295289
- Data show that viral vector-mediated transient designer nuclease expression leads to permanent and regulated dystrophin synthesis from corrected native Duchenne muscular dystrophy (DMD) alleles. PMID: 26762977
- microRNAs contribute to variable dystrophin levels in muscular dystrophy. PMID: 26321630
- Knocking down Dp71 expression can significantly inhibit the A549 xenograft tumor growth in nude mice. PMID: 26691328
顯示更多
收起更多
-
相關(guān)疾病:Duchenne muscular dystrophy (DMD); Becker muscular dystrophy (BMD); Cardiomyopathy, dilated, X-linked 3B (CMD3B)
-
亞細(xì)胞定位:Cell membrane, sarcolemma; Peripheral membrane protein; Cytoplasmic side. Cytoplasm, cytoskeleton. Cell junction, synapse, postsynaptic cell membrane.
-
組織特異性:Expressed in muscle fibers accumulating in the costameres of myoplasm at the sarcolemma. Expressed in brain, muscle, kidney, lung and testis. Most tissues contain transcripts of multiple isoforms. Isoform 15: Only isoform to be detected in heart and liver
-
數(shù)據(jù)庫(kù)鏈接:
Most popular with customers
-
-
YWHAB Recombinant Monoclonal Antibody
Applications: ELISA, WB, IHC, IF, FC
Species Reactivity: Human, Mouse, Rat
-
Phospho-YAP1 (S127) Recombinant Monoclonal Antibody
Applications: ELISA, WB, IHC
Species Reactivity: Human
-
-
-
-
-